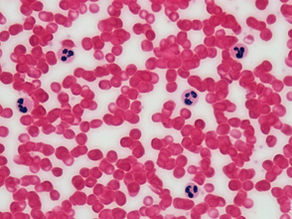
Understanding Blood Work: Why “Normal” Does Not Always Mean Optimal

top of page


Migraine Support: What to Do in the Moment, What to Work on Long Term, and How Digestion Fits Into the Picture
Migraines are not just “bad headaches.” They are complex neurologic events that can involve sensory processing, autonomic regulation, digestion, and stress physiology all at once. That is one reason migraine often shows up with nausea, bloating, reflux, constipation, food-trigger patterns, or the feeling that the stomach simply stops cooperating. A useful way to think about support is in three layers: what may help during an active migraine, what may help reduce frequency and
-
4 days ago6 min read


Beyond Pain Relief: How Bodywork and Chiropractic Support Nervous System Regulation
Bodywork and chiropractic are often talked about in terms of pain. They help reduce tension, improve movement, ease guarding, and calm irritated tissues and pain signals. That matters, and it is a big part of why people seek care. But pain relief is not the only thing happening. At the same time that bodywork and chiropractic care may help reduce pain signaling and protective muscular responses, they may also be influencing the autonomic nervous system. In other words, while
-
6 days ago5 min read


The Architecture of a Shoe: What Elevated Heels and Pointed Toes Are Really Doing to Your Body
Walk into any athletic store and you’ll see rows of shoes that look different—but are built on the same quiet assumptions: a raised heel and a tapered toe box. Most people never question it. But if you’ve ever slipped into a zero-drop, wide toe box shoe and felt something click—or something revolt—you’ve already sensed it: Footwear isn’t neutral. It’s a biomechanical instruction. This isn’t about “good vs bad shoes.”It’s about intent vs outcome—and what your body is being ask
-
Mar 234 min read


Artificial Sweeteners, Glycemic Control, and the Question of Metabolic Safety
The first time you sit across from a pediatric endocrinologist with a two-year-old who has just been diagnosed with Type 1 diabetes, the world becomes intensely numerical. Blood glucose targets.Insulin ratios.Carbohydrate counts. The language of survival becomes the language of numbers. My son was diagnosed with Type 1 diabetes when he was two years old. For nearly two decades, that diagnosis has shaped how I approach nutrition science. When a child lives with a disease that
-
Mar 126 min read

Understanding Blood Work: Why “Normal” Does Not Always Mean Optimal
Blood testing is one of the most common tools used in modern healthcare. It provides valuable insight into how different systems of the body are functioning and helps physicians identify disease, monitor treatment, and evaluate physiological changes over time. Yet most patients receive very little explanation about what their laboratory values actually mean. In many cases the conversation is brief: the labs return, the results are reviewed, and the patient hears a familiar ph
-
Mar 66 min read


After the Thaw: Working with the Medicine of
There’s a moment every spring when the land begins to move again. You can feel it before you fully see it. The air softens. Water begins to run louder through streams and creeks. Small green shoots push through soil that only weeks earlier looked frozen and lifeless. The earth shifts from winter stillness into motion. Our bodies move through a similar transition. Winter naturally draws us inward. Digestion slows, energy conserves, and the nervous system leans toward rest and
-
Mar 52 min read


The Neurobiology of Seasonal Change: Why Spring Feels Like an Internal Reset
If gravity can move the entire ocean twice a day, and solar radiation can power forests, ecosystems, and weather systems across the planet, it would be strange to imagine that human physiology sits outside those same forces. Life evolved inside repeating environmental cycles: day and night, lunar phases, and the shifting arc of the seasons. The nervous system, endocrine system, immune system, and metabolism are not static systems—they are rhythmic systems. Modern neuroscience
-
Feb 275 min read


Lipedema: When “Cellulite Legs” Are Actually a Tissue DisorderA deeper, female-centered look at the biology — and a practical, supportive plan
Most women who likely have lipedema don’t walk into an office saying, “I think I have lipedema.” They say things like: “My legs don’t match my upper body.” “My thighs are tender and bruise easily.” “My lower body feels heavy, achy, and swollen.” “My waist changes with diet… but my legs don’t.” “Everyone keeps calling it cellulite, but it hurts.” And that last part matters. Cellulite is usually cosmetic. Lipedema is often painful.They can overlap, but they are not the same sto
-
Feb 196 min read


Cellulite: What It Really Is — and What You Can Do About It
Most women notice it at some point. A shift in the thighs. Texture along the back of the legs. A dimpling pattern that wasn’t there before — or suddenly looks more obvious. And the automatic assumption? “It’s just fat.” It isn’t. Cellulite is a connective tissue remodeling pattern in the subcutaneous layer under the skin. And once you understand that, the approach to improving it changes completely. The Anatomy (Simplified but Accurate) Under the skin sits the subcutaneous la
-
Feb 192 min read


When the Body’s Autopilot Gets Loud: Perimenopause, Smooth Muscle, the ANS, and the Frontier We’re Only Starting to Map
Perimenopause has a specific kind of chaos to it. Not dramatic-in-a-romantic-way chaos — more like “why is my body suddenly doing software updates in the middle of the workday?” Bladder urgency appears out of nowhere. Blood pressure becomes inconsistent. Palpitations show up at night — sometimes clustered around hot flashes. Digestion changes. Fat tolerance shifts. Sleep gets fragile. On the surface these look like unrelated problems. In reality, they often share a hidden com
-
Feb 165 min read


The Disc and the Supply Chain Link: Why “Fixing the Back” Isn’t Just Mechanical
Most people talk about discs like they’re inert little jelly donuts between vertebrae. Cute image. Wrong vibe. A disc is living connective tissue with constraints: limited direct blood supply, slow remodeling timelines, and a heavy reliance on motion-driven nutrient exchange. That means disc health isn’t just “alignment” or “strength” or “stretching.” Those matter—but they’re only part of the story. The better story is this: A disc is a supply chain problem.And when the suppl
-
Feb 133 min read


5 Simple DIY Aromatherapy Blends to Boost Your Mood at Home
Mood can turn on a dime—sometimes because of life, sometimes because you haven’t had enough coffee, and sometimes just because… human.
-
Feb 124 min read


Body Fat Is Adaptive Living Tissue: Why body weight alone can’t explain metabolic health
Weight is easy to measure. Because of that, it often becomes the center of the metabolic conversation. But in physiology, the most convenient metric is rarely the most informative one. From an endocrine and systems-biology perspective, the more useful question is not “How much fat exists?” but “How is fat tissue behaving?” Adipose tissue can support metabolic stability or contribute to metabolic dysfunction. The difference lies in its function, not simply its volume. Adipose
-
Feb 124 min read


If You Can’t Choose Without Shame, That Isn’t Care — It’s Control
If you cannot make choices within a practitioner’s framework without being shamed—if “doctor knows best” is treated like a moral law—then what you’re in isn’t care. It’s a hierarchy. It’s the belief that because someone is trained in medicine, they somehow supersede human sovereignty… as if a person cannot possibly know their own psychology, their capacity, what they’re ready for, what they consent to, or what they choose. That isn’t wisdom. It’s authority without humility. C
-
Feb 113 min read


Why Supplements Work (and Why They Often Don’t)
Why the form, delivery, and phase matter (and why “one-a-day” is usually a fairytale) Most people meet supplements the way they meet most health advice: in the middle of chaos. They’re tired. Their digestion is weird. Sleep is fragile. Mood is unpredictable. Pain is loud. Weight won’t budge. The labs might be “normal,” but the human is not. So they do what they were trained to do in modern life: add a thing. A multivitamin. Magnesium. “Hormone support.” A gummy with a celebri
-
Feb 94 min read


Every Symptom Is Stress: The Physiology of Pain, Digestion, and Immune Drift
Stress doesn’t always feel like anxiety. Sometimes it shows up as a body that won’t unclench—aching hips, cranky shoulders, tight jaw, stiff hands, nagging SI pain...while your mind is calmly saying, “I’m fine. I sleep great.” I recently spoke with a patient who described exactly that: no anxiety, sleeping well, emotionally stable… yet her muscles and joints hurt and she suffered from severe intestinal infections in the past. It’s a pattern I see constantly, and it’s the perf
-
Feb 65 min read


Biology, Belief, and Being: One System, One Set of Mechanisms
Modern culture treats physics, biology, psychology, and spirituality as separate conversations.In reality, they are different languages describing the same system from different vantage points. At the deepest level, the human organism is not a collection of parts. It is a self-organizing, signal-driven system attempting to maintain coherence in a changing environment. Understanding health requires tracing that system back to where it actually begins: physics. The Body Is Bui
-
Feb 63 min read


Belly Breathing and the Respiratory Pump: Why Your Diaphragm Is a Circulation Tool
Most people think breathing is only about oxygen. It’s not. Breathing is also about circulation—how well your body moves blood back to the heart, how efficiently it exchanges oxygen and carbon dioxide, and how smoothly your lymphatic system clears fluid and immune “traffic.” That’s why I teach belly breathing so often at Natural Wayz. Because when you breathe into your belly (diaphragmatic breathing), you activate something physiology calls the respiratory pump (also known as
-
Feb 15 min read


The First Pillar of Healing: State
Why Reading Patterns Determines Whether Care Can Work At Natural Wayz, healing begins with state. State describes the body’s current capacity to receive, process, and respond to input. It reflects how the nervous system, musculature, breath, digestion, hormonal signaling, energy availability, and recovery systems are functioning together. Before treatment plans, protocols, or therapeutic inputs are introduced, state must be accurately read. The body communicates continuously.
-
Jan 302 min read


Your Body Is a Story, Not a Statistic
Counsel without context is incomplete. And incomplete things don’t become true just because they’re delivered with confidence, a title, or a professional tone. Context is paramount—not just in health, but in any arena where a human story is being interpreted: health histories, abuse dynamics, and gossip circles. In all three, people get harmed when a partial snapshot is treated like the whole truth. In health, context means history. The body is not a blank slate. It’s a livin
-
Jan 303 min read
bottom of page